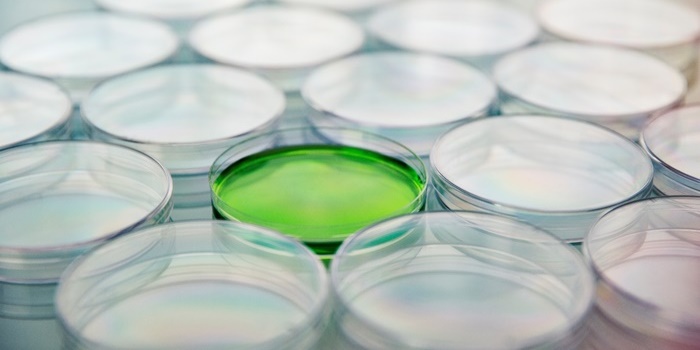

고콜레스테롤혈증으로 조사된 고지혈증의 원인, 대식세포 관련 논문

얼마 전에 언니가 회사에서 건강검진을 받았는데 갑자기 고콜레스테롤혈증이 있다는 검사 결과를 받았습니다. 처음에 검사 결과를 확인한 언니도 매우 놀랐고, 그 이야기를 전해 들은 저도 매우 놀랐습니다. 저처럼 그 이야기를 전해 들은 어머니가 할아버지도 할머니도 고콜레스테롤 혈증이었습니다.

즉, 누나는 가족력을 가진 가족성 고콜레스테롤혈증인 것 같다고 말씀하셨습니다. 그래서 평소에 건강 관리 좀 하라고 하지 않았나 엄마도 같이 심각해졌는데요. 저에게도 언니만의 문제가 아닐지 모른다고 저도 가족력으로 언제 제일의 일이 될지 모르니 지금부터라도 언니와 함께 건강관리를 해달라고 부탁했습니다. 늘 건강해 보이던 선배에게 이런 일이 생겨서 제 걱정도 되고 유전적인 일이라고 생각하니 굉장히 억울하게 느껴졌습니다. 저도 언니도 야식 같은 걸 먹고 있어도 술 담배를 피우는 것도 아닌데 유전적인 영향으로 발병 가능성이 높아지거든요.
이런게 속으로 너무 억울해도 그냥 수수방관하기보다는 예방을 할 수 있다면 미리 알아두고 예방하는 게 좋을 것 같아서 고콜레스테롤혈증, 고지혈증의 원인 등 관련 여러 가지에 대해서 알아봤거든요.

고콜레스테롤 혈증은 피 속에 포함된 콜레스테롤이 정상치를 넘어 너무 많은 증상을 말하는데요. 이게 동맥경화를 일으키기 쉽대요. 관심이 없을 때는 고지혈증과 같은 말인 줄 알았어요. 고지혈증의 원인, 예방법에 대해 자세히 살펴보면, 고지혈증은 몸의 혈액 내의 지질 농도가 높아지는 질환입니다. 고지혈증의 원인은 잘못된 생활습관으로 연령, 성별에 관계없이 많은 사람들에게 나타날 수 있어요.

지질에는 대표적인 콜레스테롤과 중성 지방이 있는데 이 중 콜레스테롤은 다시 저비중 리포단백 콜레스테롤과 고비중 리포단백 콜레스테롤로 나뉘게 됩니다. 동맥 경화의 유발에 특히 나쁜 영향을 미치는 것이 저비중 리포단백 콜레스테롤입니다. 즉 고지혈증은 저비중 리포단백 콜레스테롤 또는 중성 지방 중 하나가 높은 경우의 총칭이에요.

언니가 진단받은 고콜레 스테롤혈증은 이 중 특히 콜레스테롤이 높은 경우를 가리키는 말로 고지혈증에 포함된 여러 가지 이상 지질 혈증 중 하나입니다. 고콜레스테롤혈증이 고지혈증 현상 중 하나여서 그런지 고지혈증의 원인 등 내용을 찾을 때 두 가지가 자주 나와요. 그러다가 논문 하나를 찾게 되었어요.
[ 유기게르마늄의 아테롬성 동맥 경화증 억제 효과와 관련된 논문 ]Format : Abstract Send to J Cardiovasc Pharmacol . 2003 Feb ; 41 ( 2 ) : 171 – 7 . Long – term treatment with propagermanium suppresses atherosclerosis in WHHL rabbits . Eto Y 1 , Shimokawa H , Tanaka E , Morishige K , Fuchigami M , Ishiwata Y , Matsushima K , Takeshita A . Author information Abstract Macrophages … www.ncbi.nlm.nih.gov
논문명 : Long-term treatment with propagermanium suppresses atherosclerosis in WHHL rabbits <자연발증적으로 고콜레스테롤혈증을 가진 실험군에 유기게르마늄의 장기간 투여를 통한 아테롬 동맥경화증 억제>

이 실험은 고콜레스테롤혈증을 갖고 있으면 동맥경화증 발병 가능성이 매우 높은데 이를 유기 게르마늄이 억제한다는 내용이었습니다. 더 자세히 살펴보면 아테롬성 동맥경화증의 발병에 대식세포가 중요한 역할을 하며 단핵구 화학주성단백질(MCP-1)과 케모카인 수용체 타입2(CCR2)가 관여한다고 알려져 있습니다.

여기서 말하는 대식세포란 동물의 체내 모든 조직에 분포하여 면역을 담당하는 세포를 말합니다. 체내에 침입한 세균 등을 대식세포가 잡혀 소화하고 그에 대항하는 면역정보를 림프구에 전달하는 역할을 합니다. 대식세포는 탐식세포라고도 합니다.

유기 게르마늄은 시험관 실험에서 농도의존적으로 MCP-1이 유발시키는 THP-1 세포의 이전을 억제하였기 때문에 이를 동물실험에서 확인하였는데, 실험에서는 유기 게르마늄이 대동맥의 신생 내막 형성을 억제하고 대식세포의 양성 반응 영역을 억제하였습니다. 이로써 유기 게르마늄의 장기 처방은 동맥경화의 발병을 억제함으로써 동맥경화성 혈관질환 치료제로서의 가능성을 제시한 것입니다.

이 논문 말고도 여러 논문을 찾으면서 느낀 점은 이 세상에는 정말 많은 신약 물질이 있다는 것이었습니다. 제가 전문가가 아니라서 모든 내용을 이해하는 데는 한계가 있지만 하루빨리 고지혈증의 원인을 해결하고 가족력으로 생긴 고콜레스테롤혈증 치료제가 나왔으면 하는 생각이 듭니다.